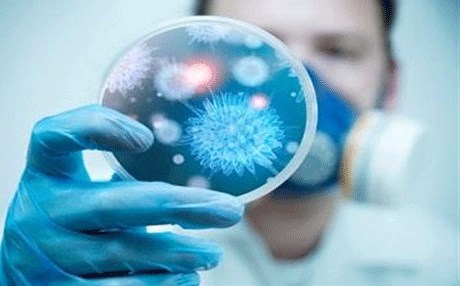

رووداو - اربيل
قال وكيل وزارة الصحة للصحة السعودية الدكتور عبدالعزيز بن سعيد إن نسبة الوفيات من الحالات المصابة بفيروس كورونا بلغت 41 في المائة منذ اكتشاف المرض في السعودية.
وتوقع ابن سعيد زيادة عدد حالات الإصابة بالأمراض التنفسية بما في ذلك الإصابة بفيروس كورونا في ظل تغير الأجواء خلال الفترة المقبلة.
هذا وتترقب وزارة الصحة السعودية قدوم وفد متخصص من منظمة الصحة العالمية، ومركز مراقبة الأمراض الأمريكي الأسبوع المقبل للاطلاع على آلية الوزارة في الرصد ومتابعة الحالات وتوعية مواطنيها.
وكشف ممثل منظمة الصحة العالمية في المملكة الدكتور حسن البشري، عن قدوم وفد من الخبراء العالميين المتخصصين في الأمراض والوبائيات إلى المملكة، حيث يضم عددا من المسؤولين من منظمة الصحة العالمية وممثلي مركز مراقبة الأمراض والسيطرة الأمريكية.
وأعلنت وزارة الصحة في السابع من الشهر الحالي، تسجيل 11 حالة إصابة جديدة بفيروس "كورونا" منذ بداية شهر فبراير شباط الجاري اثنتان منها في الهفوف، وحالة واحدة في الدمام، وحالتان في الخرج، وخمس حالات في الرياض، وحالة واحدة في نجران، مشيرة إلى أن جميع الحالات اكتسبت خارج المستشفيات.
يشار إلى أن الإجمالي الكلي لعدد حالات الإصابة بفيروس كورونا التي تخضع للعلاج حالياً بالمستشفيات بلغ 15 حالة، بما فيها الحالات الاحدى عشرة التي سجلت منذ بداية الشهر الحالي.
جدير بالذكر، أن عدد حالات الإصابة بالفيروس، منذ اكتشافه بالمملكة، بلغ 855 حالة، تماثل للشفاء منها 475 حالة، وتوفي 366 حالة، ويخضع للعلاج 14 حالة.

تعليقات
علق كضيف أو قم بتسجيل الدخول لمداخلات أكثر
أضف تعليقاً